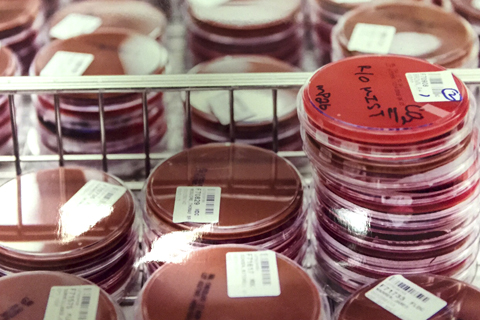

Microbiology Rotation
The goal of this 2 1/2-month rotation is for the resident to develop the necessary skills to function as a pathologist in a modern clinical pathology environment. The rotation includes a combination of bench-level training, case-based learning with infectious disease specialists, and interactive didactic sessions.
Rotation Structure
The microbiology rotation utilizes:
- Didactics
- Daily rounding in the laboratory
- Interaction with clinical laboratory scientists
- Active experience at the bench investigating epidemiologic issues and laboratory management.
Supplemental didactics are provided on a daily basis, and there are specific reading assignments.

Daily Schedule
- 9 a.m. — Problems rounds
- 10 a.m. — Bench assignment
- 11 a.m. — Laboratory rounds
- 1 p.m. — Lecture
- 2 p.m. — Infectious disease rounds (Mondays and Wednesdays); Project or test (Tuesdays); Laboratory management (Thursdays and Fridays)
- 4 p.m. — Reading
Subspecialty Conferences
- Infectious disease grand rounds
- Antimicrobial stewardship committee meeting
- Microbiology quality assurance meeting
- Microbiology laboratory test development meeting
Have Questions or Need Help?
If you have questions or would like to learn more about the Anatomic and Clinical Pathology Residency Program at Cedars-Sinai, please call or send a message to Program Coordinator, Chau Nguyen.
Department of Pathology and Laboratory Medicine
8700 Beverly Blvd., Room 8709
Los Angeles, CA 90048-1804